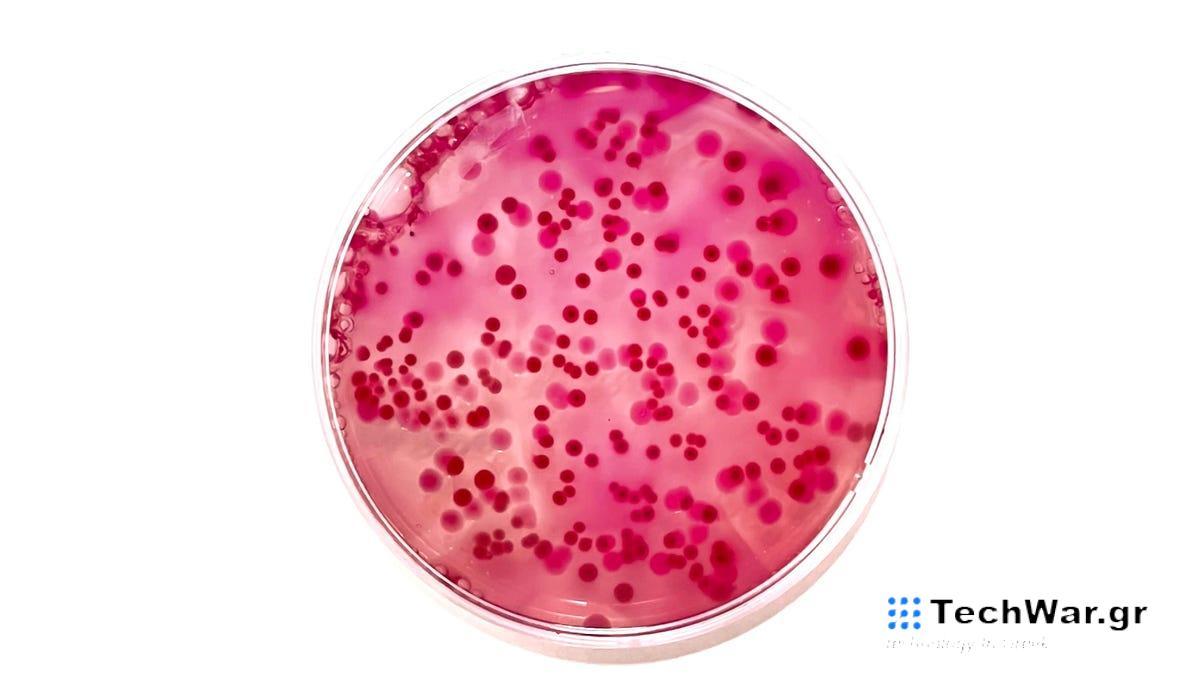
Οι επιστήμονες ανακαλύπτουν δεκάδες άγνωστα είδη βακτηρίων σε ασθενείς σε νοσοκομεία

Οι επιστήμονες ανακαλύπτουν δεκάδες άγνωστα είδη βακτηρίων σε ασθενείς σε νοσοκομεία
Σε
μι
α μελέτη
που
πραγματοποιήθηκε αυτόν τον μήνα, Ελβετοί ερευνητές είπαν ότι ανακάλυψαν γενετικά δεκάδες άγνωστα προηγουμένως βακτηριακά είδη που βρέθηκαν σε δείγματα ασθενών. Ενώ πολλά από αυτά τα νέα βακτήρια μπορεί να μην βλάψουν τον άνθρωπο, η ομάδα εντόπισε αρκετά που πιθανόν να προκαλέσουν ασθένειες.
Η έρευνα διεξήχθη από επιστήμονες από το Πανεπιστήμιο της Βασιλείας και το Πανεπιστημιακό Νοσοκομείο της Βασιλείας στην Ελβετία. Από το 2014, η ομάδα συλλέγει δείγματα αίματος ή ιστών από ορισμένους
ασθενείς
της για ένα ειδικό έργο. Οι γιατροί θα δοκιμάσουν συστηματικά δείγματα ασθενών για να βρουν βακτηρίδια που μπορεί να είναι μια εύλογη αιτία της ασθένειας κάποιου. Οι συγγραφείς της μελέτης επινόησαν έναν αλγόριθμο για τον εντοπισμό δειγμάτων όπου οι συμβατικές μέθοδοι δοκιμών απέτυχαν να εμφανιστούν τα γνωστά βακτήρια. Στη συνέχεια, ανιχνεύουν ολόκληρο το γενετικό υλικό που βρέθηκε μέσα σε αυτά τα δείγματα, ελπίζοντας να βρουν προηγουμένως ανεξερεύνητα είδη βακτηρίων.
Συνολικά, βρήκαν 61 είδη βακτηρίων που κρύβονται μέσα σε αυτά τα μυστηριώδη δείγματα. Από αυτούς, 35 φαίνεται να μην έχουν τεκμηριωθεί μέχρι τώρα. Μερικά από τα άλλα βακτηρίδια “δύσκολα ταυτοποίησης” ανακαλύφθηκαν πρόσφατα και ονομάστηκαν από άλλους ερευνητές. Τα ευρήματα της ομάδας είναι
δημοσίευσε
αυτόν τον μήνα στο περιοδικό BMC Microbiology.
«Ο νέος μας αλγόριθμος αποδείχθηκε ένα ισχυρό εργαλείο για την ανίχνευση και την αναγνώριση νέων βακτηριακών οργανισμών», έγραψαν οι συγγραφείς στην εργασία τους.
Η πλειοψηφία των βακτηρίων και άλλων μικροοργανισμών που ζουν μέσα ή πάνω στο σώμα μας είναι είτε αβλαβή είτε ωφέλιμα για την υγεία μας. Αλλά οι ερευνητές εντόπισαν επτά είδη αυτών των νέων βακτηρίων που θεωρούνται «κλινικά σχετικά», πράγμα που σημαίνει ότι είναι πιθανό να προκαλέσουν ασθένεια. Και ακόμη και συνήθως αβλαβή βακτήρια μπορεί μερικές φορές να είναι επικίνδυνα ανάλογα με τις περιστάσεις, όπως βακτήρια του δέρματος που εισέρχονται σε μια πρόσφατα ανοιγμένη πληγή ή ευκαιριακές λοιμώξεις σε άτομα που παρουσιάζουν ανοσοκαταστολή.
Αυτές τις μέρες, είναι δύσκολο για τα κλινικά εργαστήρια να υποχωρήσουν και να αποτύχουν να εντοπίσουν μια πιθανή αιτία μόλυνσης ενός ατόμου. Αλλά είμαστε ακόμα
βρίσκοντας τακτικά
νέα μικρόβια εκεί έξω. Η αλληλούχιση ολόκληρου του γονιδιώματος μπορεί να χρησιμοποιηθεί για την ανύψωση αυτών των άγνωστων μικροβίων, αλλά μπορεί να είναι μια δαπανηρή και σχετικά μακρά διαδικασία. Έτσι, οι ερευνητές ελπίζουν ότι ο αλγόριθμός τους – με το όνομα NOVA, συντομογραφία του Novel Organism Verification and
Analysis
– μπορεί να βοηθήσει άλλους επιστήμονες να επιταχύνουν αυτό το σημαντικό έργο.
Η ομάδα εργάζεται επί του παρόντος για την ονομασία των νέων ανακαλύψεών της, με δύο προτεινόμενα ονόματα
έχει ήδη υποβληθεί
προς εξέταση από την επιστημονική κοινότητα. Εξακολουθούν να συλλέγουν δείγματα και να βρίσκουν νέα βακτήρια. Μεταξύ Φεβρουαρίου 2022 και Ιουλίου 2023, σύμφωνα με την εργασία τους, εντόπισαν άλλα 21 δυνητικά νέα είδη βακτηρίων.
«Παρατηρήσαμε μια σημαντική δυναμική εδώ: χάρη στις
τεχν
ολογικές προόδους στη βακτηριολογία, δημοσιεύονται πολλά περισσότερα σχετικά με είδη βακτηρίων που ανακαλύφθηκαν πρόσφατα», δήλωσε ο συγγραφέας της μελέτης και μικροβιολόγος Daniel Goldenberger σε μια
δήλωση
.
VIA:
gizmodo.com